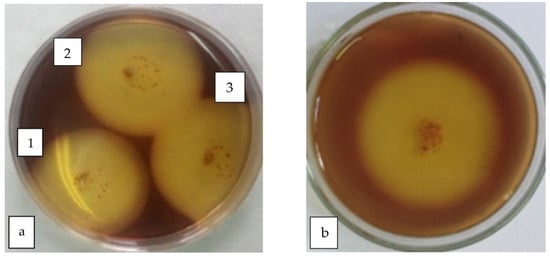

-
Unravelling the Molecular Mechanism of HIV-TAT-Tagged β-Amyloid-Induced Neurotoxicity via Lamin Fragmentation -
An Improved Approach to Protoplast Regeneration and Transfection in Banana (Musa acuminata AAA cv. Williams) -
Impact of Structural Relaxation on Protein–Protein Docking in Large Macromolecular Complexes
Journal Description
Applied Biosciences
Applied Biosciences
is an international, peer-reviewed, open access journal on all aspects of applied biosciences published quarterly online by MDPI.
- Open Access— free for readers, with article processing charges (APC) paid by authors or their institutions.
- High Visibility: indexed within ESCI (Web of Science), Scopus and other databases.
- Journal Rank: CiteScore - Q2 (Immunology and Microbiology (miscellaneous))
- Rapid Publication: manuscripts are peer-reviewed and a first decision is provided to authors approximately 23.4 days after submission; acceptance to publication is undertaken in 14.9 days (median values for papers published in this journal in the first half of 2025).
- Recognition of Reviewers: APC discount vouchers, optional signed peer review, and reviewer names published annually in the journal.
- Applied Biosciences is a companion journal of Applied Sciences.
Latest Articles
Biodegradation of Cellulose—Laboratory Scale Analysis of Bacterial Consortium Isolated from a Methanogenic Anaerobic Bioreactor
Appl. Biosci. 2025, 4(4), 58; https://doi.org/10.3390/applbiosci4040058 - 8 Dec 2025
Abstract
►
Show Figures
Urban areas and suburbs are facing many environmental problems, one of which is the increasing pollution due to the accumulation of cellulosic waste. This article presents a laboratory study on the microbial biodegradation processes of paper as a cellulosic substrate under anaerobic and
[...] Read more.
Urban areas and suburbs are facing many environmental problems, one of which is the increasing pollution due to the accumulation of cellulosic waste. This article presents a laboratory study on the microbial biodegradation processes of paper as a cellulosic substrate under anaerobic and mesophilic cultivation conditions. A bacterial consortium with cellulose-degrading activity, as well as 4 individual strains originating from a methanogenic anaerobic bioreactor (BRA), was isolated, identified, and characterized. The results demonstrated that the consortium degraded 57.14% of the cellulose matrix within 20 days. Among the individual colonies, colonies 1 and 2 (identified as Clostridium tertium and Agromyces rhizospherae) exhibited lower activities (35.37% and 34.79%, respectively), while colony 3 (Clostridium paraputrificum) displayed the highest activity (83.74%). The mixture of all four colonies achieved lower degradation (21.22%). The performed metagenomic analysis of the microbial consortium revealed a wide variety of different bacterial genera, among which Clostridium, Bacteroides, and Ruminiclostridium dominate, and the species Bacteroides oleiciplenus, Clostridium butyricum, and Ruminiclostridium papyrosolvens. Scanning electron microscopy visualized the adhesion and morphological features of the degrading microbial population. Additional experiments on the development of a laboratory model for the anaerobic biodegradation of cellulose were carried out in BRAs by using different working volumes. A maximal level of cellulose decomposition was achieved in the BRA with a working volume of 1 L, reaching 71.0% cellulose decomposition on day 20. Long-term storage studies confirmed the survival and well-preserved activity of the consortium and individual isolates, demonstrating their potential for the development of bioconversion technologies.
Full article
Open AccessArticle
Composition of Organic Fertilizers Containing Microorganisms and Their Effect on Soil Microbiological Activity and Plant Growth
by
Māris Seņkovs, Laila Dubova, Ina Alsiņa, Ingrīda Krīgere, Dagnija Lazdiņa, Viktorija Vendiņa, Sandra Marcinkeviča and Vizma Nikolajeva
Appl. Biosci. 2025, 4(4), 57; https://doi.org/10.3390/applbiosci4040057 - 5 Dec 2025
Abstract
►▼
Show Figures
The conversion of livestock manure and peat into value-added fertilizers provides an environmentally sustainable approach to nutrient recycling and waste management. In this study, organic fertilizers were formulated from poultry, pig, and cattle manure mixed with peat and wood ash, with or without
[...] Read more.
The conversion of livestock manure and peat into value-added fertilizers provides an environmentally sustainable approach to nutrient recycling and waste management. In this study, organic fertilizers were formulated from poultry, pig, and cattle manure mixed with peat and wood ash, with or without inoculation of the phosphate-solubilizing bacterium Priestia megaterium. Their efficiency was evaluated through plant growth and soil microbiological experiments involving conifer seedlings, herbaceous crops, and ornamental plants. Germination and growth trials with Norway spruce (Picea abies) and Scots pine (Pinus sylvestris) revealed clear species-specific responses: spruce seedlings performed best in substrates containing poultry or cattle manure, while pine showed enhanced growth with pig manure combined with bacterial inoculant. In pansies (Viola × wittrockiana), growth responses varied by cultivar; cattle manure enriched with bacteria increased leaf projection area, whereas poultry manure markedly suppressed growth. For cucumbers, basil, barley, radish, and garden beans, yields were lower than with mineral fertilizers, yet bacterial inoculation significantly influenced soil microbial activity by modifying respiration rates and hydrolytic enzyme intensity in plant- and manure-specific ways. The results demonstrate that microbial supplementation can alter soil biological processes and nutrient turnover, though its effects on plant productivity remain inconsistent. Further research is required to assess long-term performance under field conditions, as practical application will depend on achieving stable and reproducible results.
Full article

Figure 1
Open AccessArticle
Performance of Radiologists in Characterizing and Diagnosing Hepatic Lesions Using Dynamic Contrast-Enhanced CT with and Without Artificial Intelligence
by
Daiki Nishigaki, Atsushi Nakamoto, Takahiro Tsuboyama, Hiromitsu Onishi, Yuki Suzuki, Tomohiro Wataya, Kosuke Kita, Junya Sato, Miyuki Tomiyama, Masahiro Yanagawa, Masatoshi Hori, Shoji Kido and Noriyuki Tomiyama
Appl. Biosci. 2025, 4(4), 56; https://doi.org/10.3390/applbiosci4040056 - 3 Dec 2025
Abstract
Background: To investigate the performance of radiologists in characterizing and diagnosing hepatic lesions with and without the assistance of deep learning-based artificial intelligence (AI). Methods: This retrospective study included 83 nodules/masses from 69 patients who underwent dynamic contrast-enhanced CT of the liver. Image
[...] Read more.
Background: To investigate the performance of radiologists in characterizing and diagnosing hepatic lesions with and without the assistance of deep learning-based artificial intelligence (AI). Methods: This retrospective study included 83 nodules/masses from 69 patients who underwent dynamic contrast-enhanced CT of the liver. Image assessments were conducted by 20 radiologists. grouped according to their level of experience (10 senior and 10 junior). Each radiologist determined the probability of eight characteristics based on enhancement patterns and the diagnosis with and without AI attached to the SYNAPSE SAI viewer (FUJIFILM Corporation, Minato-ku, Japan). The reference standard for comparison was established as follows: final diagnoses were based on pathology for 39 lesions and expert imaging consensus for the remainder, while image characteristics for all lesions were determined by expert imaging consensus. Areas under the receiver operating characteristic curves (AUCs) were analyzed using the multireader multicase method. Results: Using AI significantly improved the overall AUCs for both the characterization and the diagnosis of liver lesions. Improvement was suggested for specific items, including the characterization of enhancement, nonperipheral washout, and delayed enhancement, and the diagnosis of hepatocellular carcinoma. The utilization of AI system also suggested potential improvements in the AUCs for image characterization in both the senior and junior groups. Conclusions: Using AI improved the radiologists’ performance in characterizing and diagnosing hepatic lesions. In terms of their capacity to assess imaging characteristics, improvements were observed regardless of their level of experience.
Full article
(This article belongs to the Special Issue Neural Networks and Deep Learning for Biosciences)
►▼
Show Figures

Figure 1
Open AccessArticle
Biochemical and Temperature-Related Expression and Solubility of Domain-Truncated BPM1 Variants in Escherichia coli
by
Karlo Miškec, Mateja Jagić, Lucija Markulin and Dunja Leljak-Levanić
Appl. Biosci. 2025, 4(4), 55; https://doi.org/10.3390/applbiosci4040055 - 1 Dec 2025
Abstract
►▼
Show Figures
BPM1, a representative of the plant MATH-BTB protein family comprises three conserved domains—MATH, BTB, and BACK—that facilitate diverse protein–protein interactions central to developmental processes. However, recombinant production of BPM1 and its variants in Escherichia coli are frequently constrained by low solubility and poor
[...] Read more.
BPM1, a representative of the plant MATH-BTB protein family comprises three conserved domains—MATH, BTB, and BACK—that facilitate diverse protein–protein interactions central to developmental processes. However, recombinant production of BPM1 and its variants in Escherichia coli are frequently constrained by low solubility and poor stability. In this study, we systematically optimized E. coli-based expression strategies to enable soluble production and purification of domain-truncated BPM1 variants (BPM1ΔBTB, BPM1ΔMATH, and BPM1ΔBACK). A combinatorial approach was employed: varying induction temperature, medium composition, affinity tag selection, bacterial strain, and solubility-enhancing supplements. Expression outcomes were highly dependent on specific parameter combinations. Notably, BPM1ΔBTB—previously the most recalcitrant variant—showed a marked solubility improvement when expressed as a GST fusion in E. coli Rosetta (DE3) cultivated in TB medium supplemented with MgCl2. By contrast, BPM1ΔMATH and BPM1ΔBACK displayed enhanced solubility when expressed in BL21 (DE3) cultivated in 4 × YT medium instead Rosetta (DE3) in 2 × YT medium. Constructs with N-terminal His-tags consistently resulted in poor solubility or failed expression. These results establish a framework for producing otherwise insoluble BPM1 variants and highlight a broadly applicable strategy for handling unstable proteins through tailored E. coli expression systems.
Full article

Figure 1
Open AccessArticle
Sage Essential Oil as a Natural Antigenotoxic Agent: Comet Assay Findings and Pharmacological Relevance
by
Sara Diogo Gonçalves, Igor Koval, Rita S. Matos and Ana Caramelo
Appl. Biosci. 2025, 4(4), 54; https://doi.org/10.3390/applbiosci4040054 - 19 Nov 2025
Abstract
Oxidative stress is a major contributor to genomic instability and a key factor in the etiology of various chronic diseases. Natural compounds with antioxidant and DNA-protective properties are increasingly being explored as potential preventive agents. In this study, we investigated the antigenotoxic potential
[...] Read more.
Oxidative stress is a major contributor to genomic instability and a key factor in the etiology of various chronic diseases. Natural compounds with antioxidant and DNA-protective properties are increasingly being explored as potential preventive agents. In this study, we investigated the antigenotoxic potential of Salvia sclarea L. (sage) essential oil in human peripheral blood mononuclear cells exposed to hydrogen peroxide-induced oxidative stress. The DNA damage was assessed using the in vivo Comet assay, and five concentrations of sage essential oil (0.2–3%) were evaluated, both with and without co-exposure to H2O2. The results show a dose-dependent reduction in DNA damage in cells treated with the essential oil, with significant protection observed at all tested concentrations. Chemical characterization of the essential oil revealed a high content of linalyl acetate (62.63%) and linalool (22.22%), compounds known for their antioxidant activities. These findings demonstrate the antigenotoxic capacity of S. sclarea essential oil and strengthen the evidence supporting its role as a natural agent capable of protecting human cells from oxidative DNA damage. The study contributes to the growing body of evidence on essential oils as multifunctional bioactive agents and highlights the importance of incorporating natural compounds into strategies aimed at mitigating oxidative DNA damage.
Full article
(This article belongs to the Special Issue Plant Natural Compounds: From Discovery to Application (2nd Edition))
►▼
Show Figures

Figure 1
Open AccessArticle
Unravelling the Molecular Mechanism of HIV-TAT-Tagged β-Amyloid-Induced Neurotoxicity via Lamin Fragmentation
by
Md. Selim Hossain, Vijay Sankar Ramasamy, Md. Aminul Haque, Kamarajan Rajagopalan and Il-Seon Park
Appl. Biosci. 2025, 4(4), 53; https://doi.org/10.3390/applbiosci4040053 - 18 Nov 2025
Abstract
►▼
Show Figures
The HIV-1 transactivator of transcription (TAT) protein enhances beta amyloid (Aβ42) neurotoxicity and may accelerate Alzheimer’s disease (AD)-related neuronal damage, yet its impact on nuclear architecture remains unclear. In this study, we examined the mechanism by which TAT–Aβ42 affects nuclear integrity. Exposure to
[...] Read more.
The HIV-1 transactivator of transcription (TAT) protein enhances beta amyloid (Aβ42) neurotoxicity and may accelerate Alzheimer’s disease (AD)-related neuronal damage, yet its impact on nuclear architecture remains unclear. In this study, we examined the mechanism by which TAT–Aβ42 affects nuclear integrity. Exposure to TAT–Aβ42-induced a marked elevation in intracellular calcium levels, which subsequently activated cathepsin L (CL), a lysosomal cysteine protease. Activated CL cleaved nuclear lamins, leading to nuclear envelope disruption and altered nuclear morphology. Both calcium chelation and pharmacological inhibition of CL significantly reduced lamin cleavage, highlighting a calcium-dependent CL-mediated pathway. These findings identify a novel mechanism by which TAT–Aβ42 compromises nuclear architecture, providing mechanistic insight into how HIV infection may exacerbate neurodegenerative processes in AD.
Full article

Figure 1
Open AccessReview
Synergies Between Robotics, AI, and Bioengineering—A Narrative Review Concerning the Future of Transplants
by
Domiziana Picone, Giuseppa D’Amico, Adelaide Carista, Olga Maria Manna, Stefano Burgio and Alberto Fucarino
Appl. Biosci. 2025, 4(4), 52; https://doi.org/10.3390/applbiosci4040052 - 18 Nov 2025
Abstract
The critical shortage of donor organs remains the foremost challenge in transplantation medicine. Nevertheless, advancements in robotic-assisted surgery (RAS), artificial intelligence (AI)-enhanced donor–recipient matching, and bioengineering—particularly 3D bioprinting—are revolutionizing the field. Today, RAS has evolved from an innovative technique into a reliable clinical
[...] Read more.
The critical shortage of donor organs remains the foremost challenge in transplantation medicine. Nevertheless, advancements in robotic-assisted surgery (RAS), artificial intelligence (AI)-enhanced donor–recipient matching, and bioengineering—particularly 3D bioprinting—are revolutionizing the field. Today, RAS has evolved from an innovative technique into a reliable clinical tool, with evidence indicating that it enhances surgical precision and results in better patient outcomes. Meanwhile, AI and machine learning are advancing donor–recipient matching and allocation, producing models that offer superior predictive accuracy for graft survival compared to traditional methods. Additionally, bioengineering strategies, especially 3D bioprinting and tissue engineering, are progressing from the creation of acellular scaffolds to the development of vascularized constructs, marking a significant milestone toward functional organ replacement. Despite persistent challenges such as high costs, regulatory obstacles, new structured formation programs, and the necessity for effective vascularization in engineered tissues, the integration of these disciplines is forging a new paradigm in regenerative medicine. The primary objective of this review is to synthesize multidisciplinary innovations by leveraging clinical studies and technological assessments to delineate future directions in regenerative medicine and organ transplantation.
Full article
(This article belongs to the Special Issue Anatomy and Regenerative Medicine: From Methods to Applications (2nd Edition))
►▼
Show Figures

Figure 1
Open AccessArticle
A Whole-Genome Sequencing-Based SNP Protocol for Accurate Plant Variety Identification: Application in Blueberry
by
Agnelo Furtado, Tom Gunther and Robert J. Henry
Appl. Biosci. 2025, 4(4), 51; https://doi.org/10.3390/applbiosci4040051 - 12 Nov 2025
Abstract
►▼
Show Figures
Plant variety/genotype identification has many applications in establishing the identity of plants, including the protection of intellectual property rights and the management of ex situ conservation of genetic resources. The variety may be important for operational reasons based on field performance or post-harvest
[...] Read more.
Plant variety/genotype identification has many applications in establishing the identity of plants, including the protection of intellectual property rights and the management of ex situ conservation of genetic resources. The variety may be important for operational reasons based on field performance or post-harvest processing. Blueberry (Vaccinium corymbosum L.), an economically important crop, is propagated by cuttings and commercially important accessions require an accurate variety traceability regime for the maintenance of purity, protection and policing ownership. Genome sequencing methods have improved and are feasible for use, making examination of the whole genome for all possible information on the genotype the ultimate way to distinguish plant varieties. We identified 5.3–5.5 million high-confidence homozygous SNPs with over 99% accuracy, enabling the distinction of 41 blueberry varieties. We developed a novel data-noise identification and filtering framework, which correctly determined the identity of ten unknown samples to be the Masena variety with 100% accuracy. The approach of using a data-noise filtration step minimized the impact of sequencing errors and coincident sequencing of only one allele of any heterozygous base. This SNP-based protocol with the establishment of sequence databases for all varieties of important plant species can potentially be adopted in providing reliable variety identification in critical industrial or legal applications.
Full article

Figure 1
Open AccessArticle
Construction and Evaluation of a Statistical Model for a Probit Method Simulator in Pharmacological Education
by
Toshiaki Ara, Hiroyuki Kitamura, Yu-Chi Hung and Kei-ichi Uchida
Appl. Biosci. 2025, 4(4), 50; https://doi.org/10.3390/applbiosci4040050 - 7 Nov 2025
Abstract
►▼
Show Figures
Purpose: As animal welfare becomes increasingly important, there is a corresponding desire to reduce the number of animals used in experiments. Recently, we reported on statistical models for a local anaesthetic simulator and developed a simulator for use in pharmacology education. In this
[...] Read more.
Purpose: As animal welfare becomes increasingly important, there is a corresponding desire to reduce the number of animals used in experiments. Recently, we reported on statistical models for a local anaesthetic simulator and developed a simulator for use in pharmacology education. In this study, we aimed to create a simulator for bioassay. Methods: Mice were intraperitoneally injected with a set concentration of lidocaine, and the time to the onset of convulsions or death was measured. Judgment times were set at 10 s intervals from 3 to 10 min. Parameter values were estimated by probit analysis based on the presence or absence of a reaction at each judgment time. The distributions and 95% confidence intervals (CI) of the estimated parameter values were confirmed using a nonparametric bootstrap method. Additionally, the generalization performance of the statistical model was confirmed using a five-fold cross-validation method. Monte Carlo simulations were performed using the estimated parameters from this model, and the average and distribution of the toxic dose 50% (TD50) and lethal dose 50% (LD50) were compared to those obtained from the animal experiments. Results: The parameters were properly estimated at each judgment time, and their 95% CIs were relatively narrow. The TD50 and LD50 values were similar across the five folds. Monte Carlo simulations demonstrated that the average and distribution of TD50 and LD50 were comparable to those obtained from animal experiments. Conclusions: These results suggest that a simulator based on this model is useful as an alternative to animal experiments. Therefore, our strategy will further reduce the number of experimental animals. Moreover, the method used in this study can be applied to other experiments that measure reaction time from treatment.
Full article

Figure 1
Open AccessArticle
The Inhibition of Pancreatic α-Amylase by Monomeric, Dimeric and Trimeric Procyanidins Is Dependent upon the Structural Characteristics of Inhibitors and Substrates
by
Jocelin Violeta Aguilar-López, Ana V. Arras-Gardea, Alejandra I. Martinez-Gonzalez, Emilio Alvarez-Parrilla and Laura A. de la Rosa
Appl. Biosci. 2025, 4(4), 49; https://doi.org/10.3390/applbiosci4040049 - 31 Oct 2025
Abstract
►▼
Show Figures
Procyanidins are oligomeric flavonoids with several bioactive properties. Their antidiabetic potential is related to their capacity to inhibit enzymes responsible for the absorption of dietary carbohydrates, such as pancreatic α-amylase. Procyanidins possess great structural diversity, including types of monomers and interflavanic bonds (A-
[...] Read more.
Procyanidins are oligomeric flavonoids with several bioactive properties. Their antidiabetic potential is related to their capacity to inhibit enzymes responsible for the absorption of dietary carbohydrates, such as pancreatic α-amylase. Procyanidins possess great structural diversity, including types of monomers and interflavanic bonds (A- or B-), and the degree of polymerization. However, there is a lack of evidence that systematically analyzes the effect of these structural features on their α-amylase inhibitory activity. In this paper, the activity of a mammalian pancreatic α-amylase was assessed using two different substrates, and the inhibitory activity of five commercially available procyanidins and three monomeric flavonoids was compared. The enzyme-binding sites of the eight compounds were predicted by in silico analysis to help explain the different enzyme-inhibitory activities. The inhibitory activity of procyanidins and monomeric flavonoids depended on the substrate used. A-type dimers presented the best activity against a polymeric substrate, while a B-type dimer was the best inhibitor for an oligomeric substrate. The predicted binding site for dimers and monomers was close to the active site. For the B-type trimer, the binding site was on the back side (approximately 180°) of the catalytic triad. In silico predictions suggested that dimeric procyanidins, especially A-type, could better enter the active site cavity, which could explain their superior inhibitory activity. We may conclude that inhibition of pancreatic α-amylase by procyanidins is mainly related to the type of interflavanic bond and the degree of polymerization. Dimers could be the most effective procyanidins to mildly inhibit this enzyme and present antidiabetic potential.
Full article

Graphical abstract
Open AccessArticle
Impact of Structural Relaxation on Protein–Protein Docking in Large Macromolecular Complexes
by
Raissa Santos de Lima Rosa, Ana Carolina Silva Bulla, Rafael C. Bernardi and Manuela Leal da Silva
Appl. Biosci. 2025, 4(4), 48; https://doi.org/10.3390/applbiosci4040048 - 23 Oct 2025
Abstract
►▼
Show Figures
Protein–protein docking is a cornerstone of computational structural biology, yet its reliability for large, multimeric assemblies remains uncertain. Standard workflows typically include geometry optimization or molecular dynamics equilibration to relieve local strains and improve input quality, but the extent to which these preparatory
[...] Read more.
Protein–protein docking is a cornerstone of computational structural biology, yet its reliability for large, multimeric assemblies remains uncertain. Standard workflows typically include geometry optimization or molecular dynamics equilibration to relieve local strains and improve input quality, but the extent to which these preparatory steps alter docking outcomes has not been systematically evaluated. Here, we address this question using the mitochondrial chaperonin Hsp60, a dynamic double-ring complex essential for protein folding, and MIX, a kinetoplastid-specific protein with unresolved function, as a stress test system. By comparing docking predictions across minimized, equilibrated, and ensemble-refined structures of Hsp60 in three conformational states (apo, ATP-bound, and ATP–Hsp10), we show that structural relaxation profoundly reshapes the docking landscape. Minimization alone often yielded favorable scores but localized binding, while longer MD trajectories exposed alternative sites, including central cavity, equatorial ATP pocket, and apical domain, each consistent with distinct regulatory hypotheses. These findings reveal that docking outcomes are highly sensitive to receptor preparation, especially in complexes undergoing large conformational transitions. More broadly, our study highlights an underappreciated vulnerability of docking pipelines and calls for ensemble-based and dynamics-aware approaches when predicting interactions in large biomolecular machines.
Full article

Figure 1
Open AccessReview
Nano Drug Delivery Formulations for Topical Dermal Administration of L-Ascorbic Acid and Derivatives
by
Michael Kenneth Lawson
Appl. Biosci. 2025, 4(4), 47; https://doi.org/10.3390/applbiosci4040047 - 18 Oct 2025
Abstract
►▼
Show Figures
This review considers L-ascorbic acid as a test substance in designing a dermal drug delivery system for carrying a hydrophilic, low-stability API. Actual studies of nano delivery systems carrying L-ascorbic acid are reviewed. L-ascorbic acid and other antioxidant substances are present in the
[...] Read more.
This review considers L-ascorbic acid as a test substance in designing a dermal drug delivery system for carrying a hydrophilic, low-stability API. Actual studies of nano delivery systems carrying L-ascorbic acid are reviewed. L-ascorbic acid and other antioxidant substances are present in the skin at high levels compared with blood plasma. Augmenting these L-ascorbic acid levels by topical administration may have benefit, but other antioxidants may also need to be augmented. Coadministration of other APIs with L-ascorbic acid may be beneficial, but synergetic interactions are rare and difficult to predict. Some studies reviewed used in vitro methods for quantifying skin retention of API in the living skin layers. These methods may be inadequate. In vivo mouse and rat models suggest therapeutic value of L-ascorbic acid in the skin, but since these animal skins are more permeable than human skin, evidence for good API retention in human skin is weak. Studies using inorganic or polymer nanoparticles for L-ascorbic acid include a lack information concerning skin permeability and retention. Liposome-like systems seem to be the main focus of research now. These studies challenge the understanding of skin penetration mechanisms. Predictions that positively charged deformable liposomes are superior to negatively charged non-deformable liposomes fail.
Full article

Figure 1
Open AccessReview
Nanoformulated Curcumin for Food Preservation: A Natural Antimicrobial in Active and Smart Packaging Systems
by
Edith Dube
Appl. Biosci. 2025, 4(4), 46; https://doi.org/10.3390/applbiosci4040046 - 13 Oct 2025
Abstract
►▼
Show Figures
Food spoilage and contamination remain pressing global challenges, undermining food security and safety while driving economic losses. Conventional preservation strategies, including thermal treatments, refrigeration, and synthetic additives, often compromise nutritional quality and raise sustainability concerns, thereby necessitating natural, effective alternatives. Curcumin, a polyphenolic
[...] Read more.
Food spoilage and contamination remain pressing global challenges, undermining food security and safety while driving economic losses. Conventional preservation strategies, including thermal treatments, refrigeration, and synthetic additives, often compromise nutritional quality and raise sustainability concerns, thereby necessitating natural, effective alternatives. Curcumin, a polyphenolic compound derived from Curcuma longa, has demonstrated broad-spectrum antimicrobial, antioxidant, and anti-inflammatory activities, making it a promising candidate for food preservation. However, its poor solubility, instability, and low bioavailability limit direct applications in food systems. Advances in nanotechnology have enabled the development of nanoformulated curcumin, enhancing solubility, stability, controlled release, and functional efficacy. This review examines the antimicrobial mechanisms of curcumin and its nanoformulations, including membrane disruption, oxidative stress via reactive oxygen species, quorum sensing inhibition, and biofilm suppression. Applications in active and smart packaging are highlighted, where curcumin nanoformulation not only extends shelf life but also enables freshness monitoring through pH-responsive color changes. Evidence across meats, seafood, fruits, dairy, and beverages shows improved microbial safety, oxidative stability, and sensory quality. Multifunctional systems, such as hybrid composites and stimuli-responsive carriers, represent next-generation tools for sustainable packaging. However, challenges remain with scale-up, migration safety, cytotoxicity, and potential promotion of antimicrobial resistance gene (ARG) transfer. Future research should focus on safety validation, advanced nanocarriers, ARG-aware strategies, and regulatory frameworks. Overall, nanoformulated curcumin offers a natural, versatile, and eco-friendly approach to food preservation that aligns with clean-label consumer demand.
Full article

Figure 1
Open AccessArticle
Structural and Dynamic Properties of Chemically Crosslinked Mammalian and Fish Gelatin Hydrogels
by
Vladislav Abramov, Ivan V. Lunev, Ilnaz T. Rakipov, Alena A. Nikiforova, Mariia A. Kazantseva, Olga S. Zueva and Yuriy F. Zuev
Appl. Biosci. 2025, 4(4), 45; https://doi.org/10.3390/applbiosci4040045 - 2 Oct 2025
Abstract
►▼
Show Figures
Gelatin is a collagen-derived biopolymer widely used in food, pharmaceutical and biomedical applications due to its biocompatibility and gelling ability. However, gelatin hydrogels suffer from unstable mechanical strength, limited thermal resistance and susceptibility to microbial contamination. The main aim of the present study
[...] Read more.
Gelatin is a collagen-derived biopolymer widely used in food, pharmaceutical and biomedical applications due to its biocompatibility and gelling ability. However, gelatin hydrogels suffer from unstable mechanical strength, limited thermal resistance and susceptibility to microbial contamination. The main aim of the present study is to investigate the influence of gelatin cryostructuring followed by photo-induced menadione sodium bisulfite (MSB) chemical crosslinking on the structural and functional characteristics of mammalian and fish gelatin hydrogels. The integration of scanning electron microscopy, dielectric spectroscopy and rheological experiments provides a comprehensive view of the of molecular, morphological and mechanical properties of gelatin hydrogels under photo-induced chemical crosslinking. The SEM results revealed that crosslinked hydrogels are characterized by enlarged pores compared to non-crosslinked systems. For mammalian gelatin, multiple pores with thin partitions are formed, giving a dense and stable polymer network. For fish gelatin, large oval pores with thickened partitions are formed, preserving a less stable ordered architecture. Rheological data show strong reinforcement of the elastic and thermal stability of mammalian gelatin. The crosslinked mammalian system maintains the gel state at higher temperatures. Fish gelatin exhibits reduced elasticity retention even after crosslinking because of a different amino acid composition. Dielectric results show that crosslinking increases the portion of bound water in hydrogels considerably, but for fish gelatin, bound water is more mobile, which may explain weaker mechanical properties.
Full article

Figure 1
Open AccessArticle
Sustainable Fabrication of Zinc Oxide Nanoparticles Using Assam Green Tea Extract with Promising Oral Antimicrobial Potential
by
Ampa Jimtaisong, Nisakorn Saewan and Nattakan Panyachariwat
Appl. Biosci. 2025, 4(3), 44; https://doi.org/10.3390/applbiosci4030044 - 18 Sep 2025
Abstract
►▼
Show Figures
In this study, zinc oxide nanoparticles (ZnO NPs) were synthesized via a green chemistry approach using aqueous extract of Camellia sinensis var. assamica (Assam green tea) as a bioreductant and stabilizing agent. Phytochemical analysis of the extract revealed high levels of phenolics (338.57
[...] Read more.
In this study, zinc oxide nanoparticles (ZnO NPs) were synthesized via a green chemistry approach using aqueous extract of Camellia sinensis var. assamica (Assam green tea) as a bioreductant and stabilizing agent. Phytochemical analysis of the extract revealed high levels of phenolics (338.57 ± 3.90 mg GAE/mL) and flavonoids (123.92 ± 1.34 µg QE/mL), along with strong antioxidant and reducing activity, supporting its efficacy in nanoparticle formation. ZnO NPs were synthesized at various extract concentrations, with 25% yielding optimal characteristics based on UV–Vis spectrophotometry (λMax ≈ 390–410 nm). Structural characterization using XRD confirmed the hexagonal wurtzite phase, and SAXS indicated particle sizes of 58–60 nm. FE-SEM analysis showed semi-spherical agglomerated particles ranging from 74 to 76 nm, while EDX verified the elemental purity of Zn and O. FT-IR spectroscopy confirmed the presence of Zn–O stretching and phytochemical residues on the nanoparticle surface. Stability studies over four weeks revealed red shifts in absorbance and reduced peak intensity at ambient and elevated temperatures, suggesting nanoparticle agglomeration. Antimicrobial assays demonstrated strong antifungal activity of the ZnO NP solution against Candida albicans and, upon concentration, significant antibacterial activity against Streptococcus mutans. The synthesized ZnO NPs exhibit promising potential as eco-friendly antimicrobial agents, particularly for applications in oral healthcare.
Full article

Graphical abstract
Open AccessArticle
Evaluation of the Effects of Demineralization and Decellularization for the Development of a Decellularized Bone Matrix from Tuna (Thunnus albacares) Bone
by
Zesreal Cain Bantilan, Marionilo Labares, Jr., Johnel Alimasag, Kit Dominick Don Valle, Chancy Louisse Barlisan, Elizer Eleccion and Ronald Bual
Appl. Biosci. 2025, 4(3), 43; https://doi.org/10.3390/applbiosci4030043 - 12 Sep 2025
Abstract
The exploration of alternative sources of extracellular matrix (ECM) is driven by increasing demand and the need for sustainable biomaterials. Tuna (Thunnus albacares) bones, a by-product of the fishing industry, represent a potential ECM source due to their abundance, collagen-rich composition,
[...] Read more.
The exploration of alternative sources of extracellular matrix (ECM) is driven by increasing demand and the need for sustainable biomaterials. Tuna (Thunnus albacares) bones, a by-product of the fishing industry, represent a potential ECM source due to their abundance, collagen-rich composition, and biocompatibility. This study investigated the effects of demineralization using hydrochloric acid (HCl) at concentrations of 0.5 M and 1.0 M for varying durations (0.5, 1, 6, 12, and 24 h), and decellularization using sodium dodecyl sulfate (SDS) and Triton X-100 (TX100) at concentrations of 0.1%, 0.5%, and 1.0%. Demineralization effectively reduced inorganic content, with residual calcium levels dropping below 5% after 6 h. Kinetic analysis indicated a second-order reaction, and ATR–FTIR spectra confirmed the disappearance of phosphate and carbonate peaks alongside the preservation of amide bands. Demineralized bone matrix (dBM) retained good thermal stability and mechanical properties. Decellularization efficiency was assessed through H&E staining, dsDNA quantification, and SDS-PAGE analysis. Decellularized extracellular bone matrix (dEBM) treated with 1.0% SDS showed the lowest dsDNA levels (14.00 ± 7.94 ng/mg) and absence of cellular material. SDS-PAGE confirmed type I collagen preservation, particularly in samples treated with ≤0.5% SDS or TX100. This study establishes that tuna fish bones can be effectively processed into ECM, supporting their potential as a sustainable biomaterial for advanced biomedical applications.
Full article
(This article belongs to the Special Issue Anatomy and Regenerative Medicine: From Methods to Applications (2nd Edition))
►▼
Show Figures

Figure 1
Open AccessArticle
An Improved Approach to Protoplast Regeneration and Transfection in Banana (Musa acuminata AAA cv. Williams)
by
Pradeep Chand Deo, Jean-Yves Paul, Anthony James, Rob Harding and James Dale
Appl. Biosci. 2025, 4(3), 42; https://doi.org/10.3390/applbiosci4030042 - 1 Sep 2025
Abstract
►▼
Show Figures
Protoplasts offer a promising alternative to embryogenic cell suspensions (ECS) for gene editing in banana, potentially overcoming several limitations associated with ECS-based transformation systems. This study aimed to optimize protoplast isolation and regeneration in Cavendish banana (cv. Williams) and to assess their suitability
[...] Read more.
Protoplasts offer a promising alternative to embryogenic cell suspensions (ECS) for gene editing in banana, potentially overcoming several limitations associated with ECS-based transformation systems. This study aimed to optimize protoplast isolation and regeneration in Cavendish banana (cv. Williams) and to assess their suitability for transient gene expression. Enzymatic digestion of ECS using cellulase and macerozyme consistently yielded approximately 3 × 106 protoplasts per milliliter of settled cell volume. Protoplast yield was further enhanced, by approximately threefold, through the addition of an antioxidant mixture (ascorbic acid, citric acid and L-cysteine) combined with 0.01% bovine serum albumin. Polyethylene glycol-mediated transfection with a green fluorescent protein reporter gene yielded transient expression in approximately 0.75% of protoplasts five days post-transfection. While phenotypically normal plants were regenerated from untransfected protoplasts after 12 weeks in agarose bead culture with conditioned liquid medium, no regeneration was observed from transfected cells. These findings establish a reproducible protocol for protoplast isolation and plant regeneration in Cavendish banana and provide insight into the barriers limiting successful regeneration following transfection.
Full article

Figure 1
Open AccessArticle
Gamma Irradiation Enhances the In Vitro Biocontrol Potential of Trichoderma Species Against Major Rice Pathogens Rhizoctonia solani and Pyricularia oryzae
by
Bang Diep Tran, Huyen Thanh Tran, Dang Sang Hoang, Hong Nhung Tran, Ngoc Khanh Linh Dao, Xuan Vinh Le, Xuan An Tran, Hong Duong Nguyen, Thi Thu Hong Le and Thi Huyen Do
Appl. Biosci. 2025, 4(3), 41; https://doi.org/10.3390/applbiosci4030041 - 20 Aug 2025
Abstract
Improving the efficacy of microbial biocontrol agents is a pivotal strategy for sustainable management of rice blast and sheath blight caused by Pyricularia oryzae and Rhizoctonia solani, respectively, in Vietnam. In this study, Trichoderma sp. TVN-A0 and Trichoderma sp. TVN-H0 were irradiated
[...] Read more.
Improving the efficacy of microbial biocontrol agents is a pivotal strategy for sustainable management of rice blast and sheath blight caused by Pyricularia oryzae and Rhizoctonia solani, respectively, in Vietnam. In this study, Trichoderma sp. TVN-A0 and Trichoderma sp. TVN-H0 were irradiated by gamma to generate mutants for screening the enhanced antagonistic activity against P. oryzae and R. solani. The potential mutants were screened by antifungal metabolite production via the cellophane membrane assay (ICM), antagonistic performance through dual culture confrontation assays (IDC), volatile organic compound bioassays (IVOCs), and chitinase activity. As a result, among five potential mutants derived from each wild-type strain (AM1-AM5 and HM1-HM5), mutant AM2 originated from TVN-A0, and mutant HM2 derived from TVN-H0 demonstrated the highest inhibition rates and chitinase activities. The AM2 exhibited ICM of 96.71% against R. solani, 92.57% against P. oryzae, IDC of 87.76%, and IVOCs of 83.57%, while HM2 possessed ICM of 95.33% against R. solani, 85.28% against P. oryzae, IDC of 91.24%, and IVOCs of 79.33%. The genetic differences among mutants and their parents were investigated by RAPD. The non-GMO AM2 and HM2 mutants are promising candidates for biocontrol of the diseases caused by P. oryzae and R. solani in Vietnam.
Full article
(This article belongs to the Special Issue Experimental Biology: From Methods to Applications—Under the Auspices of the Italian Society of Experimental Biology, SIBS-1925)
►▼
Show Figures

Figure 1
Open AccessArticle
Immunocapture RT-qPCR Method for DWV-A Surveillance: Eliminating Hazardous Extraction for Screening Applications
by
Krisztina Christmon, Eugene V. Ryabov, James Tauber and Jay D. Evans
Appl. Biosci. 2025, 4(3), 40; https://doi.org/10.3390/applbiosci4030040 - 6 Aug 2025
Abstract
►▼
Show Figures
Deformed wing virus (DWV) is a major contributor to honey bee colony losses, making effective monitoring essential for apiary management. Traditional DWV detection relies on hazardous RNA extraction followed by RT-qPCR, creating barriers for widespread surveillance. We developed an immunocapture RT-qPCR (IC-RT-PCR) method
[...] Read more.
Deformed wing virus (DWV) is a major contributor to honey bee colony losses, making effective monitoring essential for apiary management. Traditional DWV detection relies on hazardous RNA extraction followed by RT-qPCR, creating barriers for widespread surveillance. We developed an immunocapture RT-qPCR (IC-RT-PCR) method for screening DWV-A infections by capturing intact virus particles from bee homogenates using immobilized antibodies. Validation demonstrated strong correlation with TRIzol®-based extraction (r = 0.821), with approximately 6 Ct reduced sensitivity, consistent with other published immunocapture methods. Performance was adequate for moderate–high viral loads, while TRIzol® showed superior detection for low-dose infections. Laboratory-produced reverse transcriptase showed equivalent performance to commercial enzymes, providing cost savings. IC-RT-PCR eliminates hazardous chemicals and offers a streamlined workflow for surveillance screening where the safety and cost benefits outweigh the sensitivity reduction. This method provides a practical alternative for large-scale DWV-A surveillance programs, while TRIzol® remains preferable for low-level detection and diagnostic confirmation.
Full article

Figure 1
Open AccessArticle
Comparison of Susceptibility to Microbiological Contamination in FAMEs Synthesized from Residual and Refined Lard During Simulated Storage
by
Samuel Lepe-de-Alba, Conrado Garcia-Gonzalez, Fernando A. Solis-Dominguez, Rafael Martínez-Miranda, Mónica Carrillo-Beltrán, José L. Arcos-Vega, Carlos A. Sagaste-Bernal, Armando Pérez-Sánchez, Marcos A. Coronado-Ortega and José R. Ayala-Bautista
Appl. Biosci. 2025, 4(3), 39; https://doi.org/10.3390/applbiosci4030039 - 4 Aug 2025
Abstract
►▼
Show Figures
The present research features an experimental comparative design and the objective of this work was to determine the susceptibility to microbiological contamination in fatty acid methyl esters (FAMEs) and the FAME–water interface of residual and refined lard, large volume simulating storage conditions as
[...] Read more.
The present research features an experimental comparative design and the objective of this work was to determine the susceptibility to microbiological contamination in fatty acid methyl esters (FAMEs) and the FAME–water interface of residual and refined lard, large volume simulating storage conditions as fuel supply chain, and to identify the microorganisms developed. The plates were seeded according to ASTM E-1259 and the instructions provided by the manufacturer of the Bushnell Haas agar. Microbiological growth was observed at the FAME–water interface of FAME obtained from residual lard. Using the MALDI-TOF mass spectrometry technique, Pseudomonas aeruginosa and Streptomyces violaceoruber bacteria were identified in the residual lard FAMEs, with the latter being previously reported in FAMEs. The implications of microorganism development on the physicochemical quality of FAMEs are significant, as it leads to an increase in the acid index, which may negatively impact metals by inducing corrosion. The refined lard FAMEs did not show any development of microorganisms. The present research concluded that residual lard tends to be more prone to microbiological attack if the conditions of water and temperature affect microbial growth. The findings will contribute to the knowledge base for a safer introduction of FAMEs into the biofuel matrix.
Full article

Figure 1
Highly Accessed Articles
Latest Books
E-Mail Alert
News
Topics
Topic in
Applied Biosciences, Applied Sciences, Fermentation, Marine Drugs, Microorganisms, Phycology
Microalgae: Current Trends in Basic Research and Applications
Topic Editors: Nhuan Nghiem, Tae Hyun KimDeadline: 31 March 2026
Topic in
Applied Microbiology, IJMS, Microbiology Research, Microorganisms, Veterinary Sciences, Applied Biosciences
Microbiota Diversity and Its Broader Biological Implications Across Human and Animal Health
Topic Editors: Giovanna Liguori, Luc van Nassauw, Anna CostagliolaDeadline: 30 April 2026
Topic in
Applied Biosciences, Applied Microbiology, Fermentation, Marine Drugs, Microorganisms
Microbial Cell Factories for Natural Products
Topic Editors: Carlos Barreiro, Ana Ibáñez, José L. BarredoDeadline: 31 May 2026
Topic in
Applied Biosciences, Applied Microbiology, JoF
Fungi in the Circular Economy
Topic Editors: Giuseppe Venturella, Lillian BarrosDeadline: 31 July 2026
Special Issues
Special Issue in
Applied Biosciences
Feature Review for Applied BiosciencesGuest Editor: Robert HenryDeadline: 31 December 2025
Special Issue in
Applied Biosciences
Plant Natural Compounds: From Discovery to Application (2nd Edition)
Guest Editors: Adriana Basile, Viviana Maresca, Alessia PostiglioneDeadline: 31 December 2025
Special Issue in
Applied Biosciences
Neural Networks and Deep Learning for Biosciences
Guest Editor: Nikolaos KourkoumelisDeadline: 31 January 2026
Special Issue in
Applied Biosciences
Experimental Biology: From Methods to Applications—Under the Auspices of the Italian Society of Experimental Biology, SIBS-1925
Guest Editors: Francesco Cappello, Maria Grazia PalmeriniDeadline: 20 February 2026